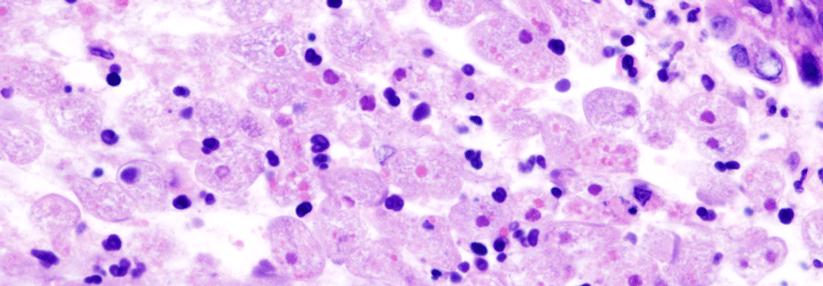

Infizierte Tumorpatienten ambulant führen: Aktuelles zur Behandlung von Virusinfektionen und febrilen Neutropenien
 Vermehrt sich VZV nach einer Latenzphase, kann es eine Gürtelrose bewirken.
© Wikimedia/Fixi
Vermehrt sich VZV nach einer Latenzphase, kann es eine Gürtelrose bewirken.
© Wikimedia/Fixi
Natürlich gelten die Regeln und Leitlinien, die für die stationäre Infektionstherapie entwickelt wurden, im ambulanten Bereich genauso. Das gilt insbesondere für die 2017 neu erstellte Leitlinie zum Fieber unklarer Genese (FUO). „Es gibt aber Aspekte, die in der ambulanten Versorgung anders sind“, betonte Dr. Sandherr.
Kernfrage Nr. 1: Wie schützt man ambulant behandelte Patienten vor Virusinfektionen?
Die Patienten in der onkologischen Praxis sind anders als im stationären Sektor – keine akuten Leukämien, keine transplantierten Patienten, keine Aplasie unter Chemotherapie, sondern meist solide Tumoren. Entsprechend anders sehen auch die Risiken aus.
Wenn ambulante Tumorpatienten an einer…
Liebe Leserin, lieber Leser, aus rechtlichen Gründen ist der Beitrag, den Sie aufrufen möchten, nur für medizinische Fachkreise zugänglich. Wenn Sie diesen Fachkreisen angehören (Ärzte, Apotheker, Medizinstudenten, medizinisches Fachpersonal, Mitarbeiter der pharmazeutischen oder medizintechnischen Industrie, Fachjournalisten), loggen Sie sich bitte ein oder registrieren sich auf unserer Seite. Der Zugang ist kostenlos.
Benutzeranmeldung
Bitte geben Sie Ihren Benutzernamen und Ihr Passwort ein, um sich an der Website anzumelden.
Bei Fragen zur Anmeldung senden Sie bitte eine Mail an online@medical-tribune.de.